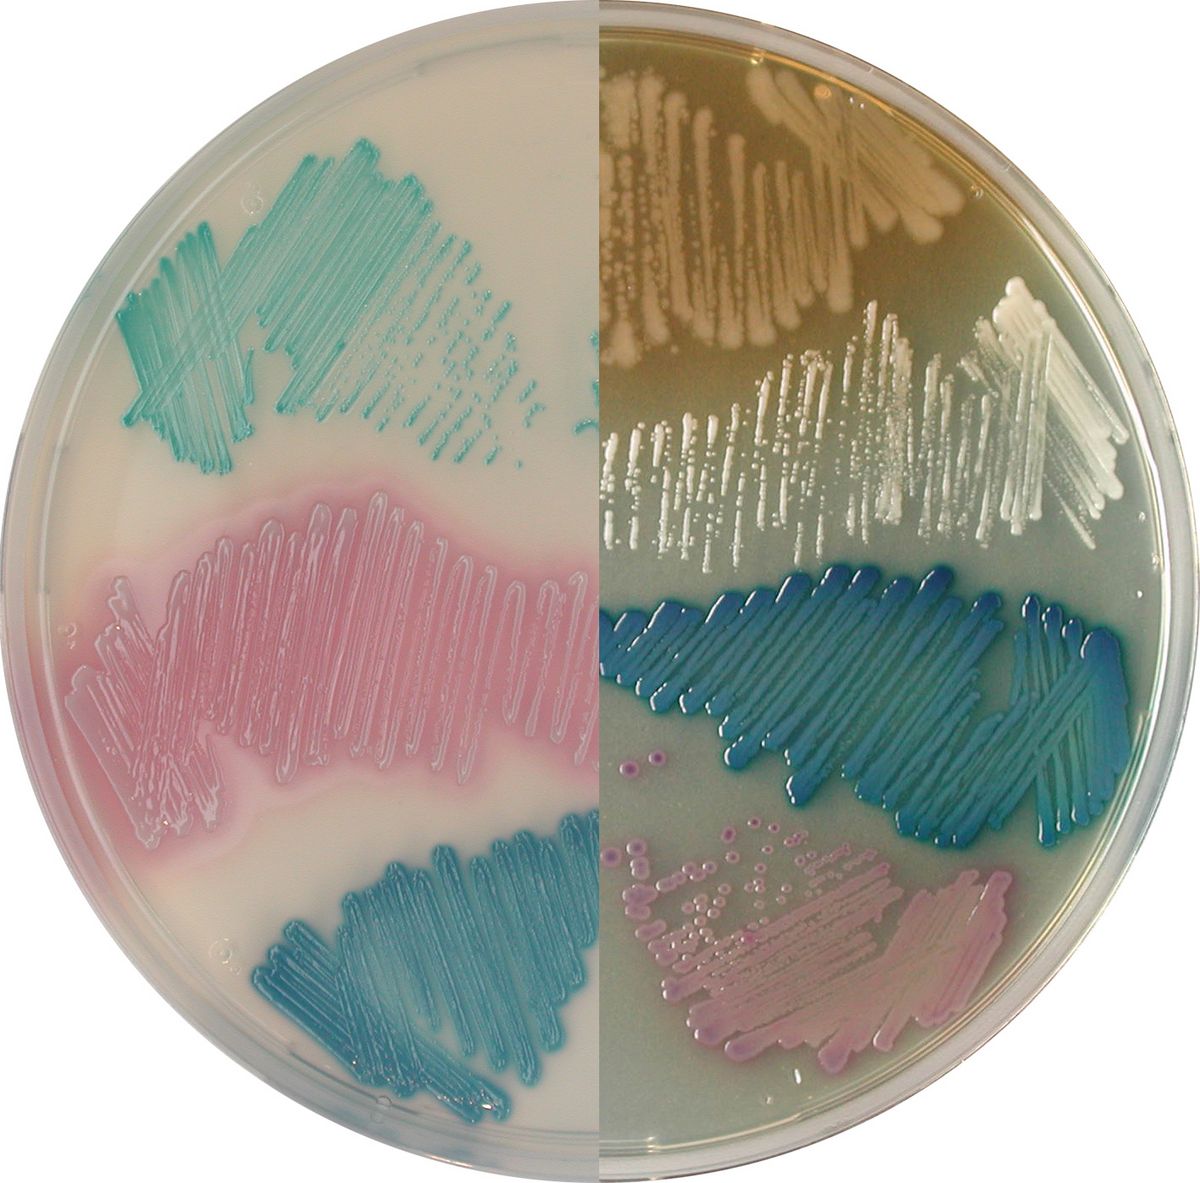
CHROMagar™ Mastitis - 2 x 5000 ml

SQ001
For Rapid detection of Salmonella species including S. typhi, S. paratyphi and Salmonella lactose positive strains
Package size: 1000 ml
DKK 750,00
DKK 6.000,00
Not in stock, delivery 1-2 weeks
Two chromogenic media for isolation and differentiation of the main Gram (+) the main Gram (-) pathogens involved in Mastitis infections.
This kit consists of two different culture media, one for the Gram positive bacteria (GP) and the other for the Gram negative bacteria (GN).The Gram (+) product/Mastitis GP is composed of powder base and a supplement, and the Gram (-)product /Mastitis GN is composed of a single powder base.
MEDIUM PERFORMANCE:
1. Rapid and simple differentiation, facilitating the choice of appropriate and optimised therapies.
2. 24 hour detection minimising the time to make the best treatment decisions.
3. Two-in-one plate allowing in one glance the identification of the whole spectrum of Gram (+) and Gram (-) bacteria.
TYPICAL APPEARANCE OF MICROORGANISMS:
CHROMagar™ MastitisGP
S. agalactiae → blue-green
S. uberis → metallic blue
S. aureus → pink
Gram negative bacteria → inhibited
CHROMagar™Mastitis GN
E. coli → red
Klebsiella, Enterobacter, Citrobacter → metallic blue (+/- red halo)
Proteus → brown halo
Pseudomonas → cream, translucent
C. albicans → white, opaque, small
Gram positive bacteria → inhibited
Lack of Mastitis infection spread control in a cattle is known as a cause of heavy economic losses to milk producers and to the dairy industry. Mastitis causes a reduction in the quantity/quality of milk output, increased veterinary expenses due to excessive use of medications, increased risk of residues in the milk/meat and, consequently the possibility of damage to public health.
Being a multifactor disease, caused by multiple pathogens, Mastitis control remains a difficult issue. Although, adequate antibiotic therapy can only be oriented if the pathogens causing the infection are clearly identified.
In order to avoid the indiscriminate use of antibiotics in cattle and reduce the economic burden of clinical mastitis, it is critical to implement an on-farm rapid identification of milk pathogens.